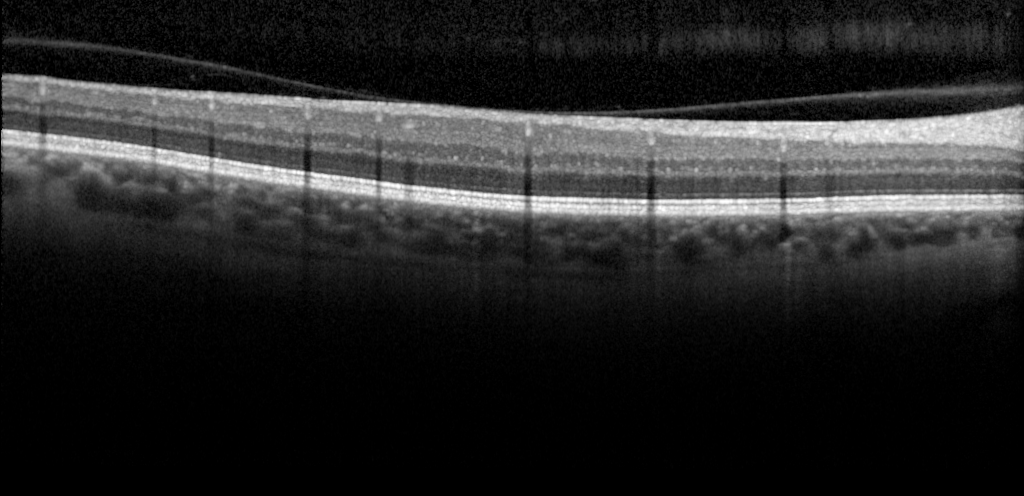

Our Mission at Mind+
Our mission is to provide the healthcare industry with efficient and reliable medical image analysis solutions through innovative artificial intelligence technology. We strive to assist physicians in making more accurate diagnoses and treatments, thereby improving the quality of life for patients.
About Mind+ AI
Our Philosophy
At Mind+ AI, we firmly believe that applying artificial intelligence to analyze medical images represents a technology innovation with boundless potential and profound impact. In the digital era, our team is committed to providing healthcare professionals with efficient and dependable medical image analysis solutions, empowering them to make more precise diagnoses and treatments, while helping to improve the overall health outcomes of their patients.
How We Can Help
Healthcare Institutions
Mind+ leverages advanced artificial intelligence technology and professional medical imaging analysis expertise to provide efficient and reliable medical image analysis solutions, empowering healthcare institutions and doctors to make more accurate diagnoses and treatments, and improving the quality and efficiency of medical services.
Patients
Mind+ medical image analysis solutions can help patients obtain accurate diagnoses and treatments more quickly, improving their health status and quality of life.
Customized Solutions
In addition to standard medical image analysis solutions, Mind+’s team can provide customized solutions tailored to meet the specific needs of each user, ensuring that every partner receives the most suitable medical image analysis service.
Partners
Mind+ is honored to have established partnerships with several renowned institutions, including the CUHK Ophthalmology Center, Advance Biophotonic Lab, and Eyecare Plus Limited. These institutions possess rich professional knowledge and experience in the fields of ophthalmology and medical image analysis, and actively promote innovation and development of technology and services.
Through close collaboration with these partners, Mind+ is able to better understand customer needs and feedback, continuously improve solutions and service quality, and provide customers with more efficient, precise, and reliable medical image analysis solutions and services, ultimately enhancing the quality and efficiency of medical services.
News
Recent Goals
One of Mind+’s recent goals is to develop efficient and accurate Optical Coherence Tomography (OCT) image segmentation and classification algorithms to provide better diagnostic and treatment support for ophthalmologists. We will leverage the most advanced artificial intelligence technology and medical image analysis expertise to continuously optimize our algorithms and improve the accuracy and efficiency of diagnoses.
At the same time, we will work closely with ophthalmology healthcare institutions and experts to understand their needs and feedback, ensuring that our algorithms can meet the practical application scenarios and requirements of our customers. We believe that through our efforts, we can bring more efficient, accurate, and reliable services and support to the ophthalmology healthcare industry.
We are confident that this work will have a significant impact on ophthalmology healthcare, helping doctors diagnose and treat eye diseases more quickly and accurately, and providing patients with better medical experiences and treatment outcomes.

Join Hands with Us
Mind+ provides AI model development services, offering customized AI model development resources to organizations that want to leverage artificial intelligence to advance their businesses. Our team has professional expertise in AI algorithms and technology, and can provide efficient and reliable AI model development solutions for organizations.
Whether you want to improve business efficiency with AI technology or develop new AI application products, we can provide tailored AI model development services based on your needs and actual application scenarios, bringing you greater value.
Our services include data collection and processing, AI model design and testing, and other aspects, to ensure that your organization obtains efficient and reliable AI model development solutions. In addition, our team will work closely with you to understand your needs and feedback, adjust and optimize AI models based on actual application scenarios, and ensure that you get the ideal products and services.


